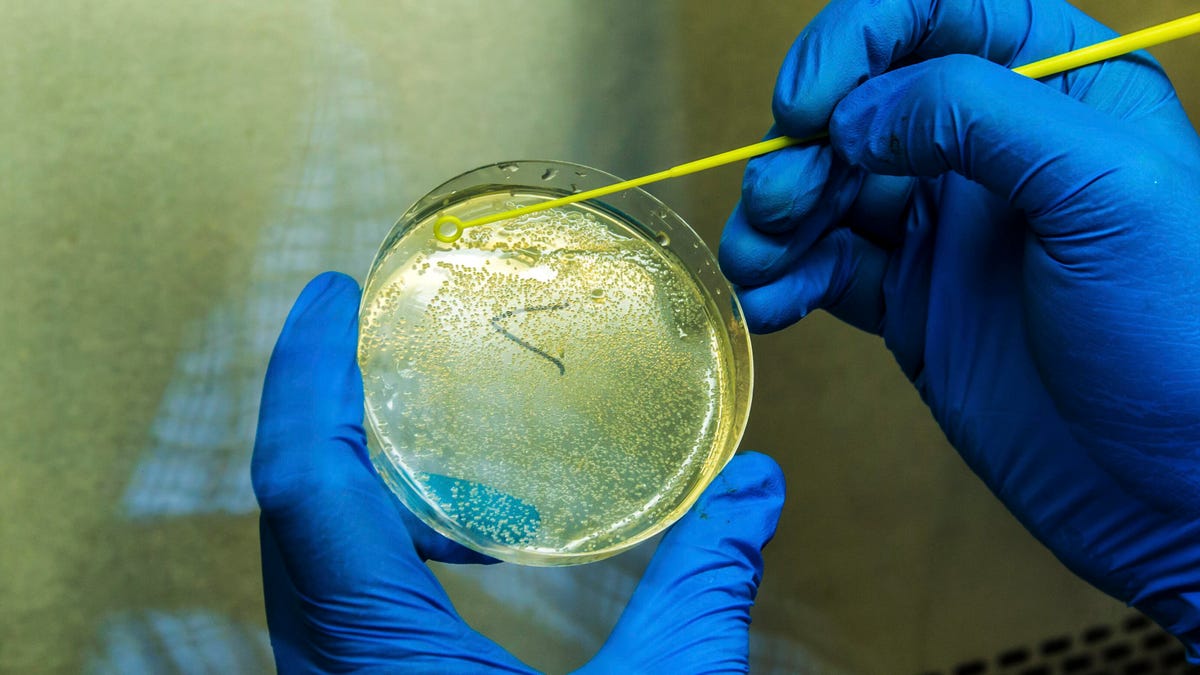
Coronavirus testing

With coronavirus cases continuing to grow in the US and around the world, and projections that more people could become infected as we head into flu season, questions abound about who should get tested and how long it could take to find out the results.
Fortunately, many states have made it easier to get coronavirus tests than in the first months of the pandemic, but the amount of time it takes to get your results back varies based on where you go and which test is administered.
In most cases, the testing facility should let you know a time frame for getting your coronavirus results back, but that can vary from hours to even a week or longer, especially if confusion over flulike versus coronavirus-like symptoms causes test result delays. Here's what we know about when to get tested, how long it takes to get tested and how to find out your results.
When should I get a coronavirus test?
If you've been in contact with someone who has tested positive for COVID-19, contact your doctor or local healthcare provider for further instructions. Depending on how long it's been since exposure, you may be asked to get a test immediately or make an appointment.
The CDC recommends getting a coronavirus test for the following reasons:Â
- If you're experiencing symptoms of COVID-19.Â
- If you've had close contact with someone -- within 6 feet of an infected person for at least 15 minutes -- with a positive COVID-19 test.
- If you've been asked by your healthcare provider to get a test.
Where can I get a COVID-19 test?
Now that tests are more widely available, finding a testing site near you should be easier.Â
Some areas have drop-in testing centers where you can walk up. Others may require a doctor's order and an appointment with a testing facility, a measure that could help avoid crowds that would overwhelm the testing site and staff. Contact your local testing center to get a sense of what to expect. It's likely you will need to wear a face mask to get tested.
If you're a high-risk patient or experiencing severe symptoms, such as trouble breathing, you should seek medical attention immediately. Call your doctor for a referral to a testing clinic in your area.Â
What is the coronavirus test like?
When you go to get screened for the coronavirus you'll either be directed to a clinic or to an outdoor, drive-thru testing site where a medical practitioner comes to you. If you're waiting in a medical facility, it's recommended by the Centers for Disease Control and Prevention that you wear a face covering to prevent spreading the virus to others. Note that many facilities may require you to wear a face mask.
One common type of testing for COVID-19 today is a nose swab that's similar to screening for other flu viruses. In the earliest COVID-19 nasal tests, the doctor would swab the inside of your nose for several seconds with a long, single-use tool that looks like a giant Q-Tip and reaches the upper part of the throat. Lately, a more shallow nasal swab in one or both nostrils is also administered.
Antibody testing, which requires a blood sample, is also more available. That test works like other blood draws, where a medical professional sterilizes your arm (usually around the inner elbow crease,) inserts a needle into your vein and takes a small sample of blood.
Regardless of how you're tested, the sample is sealed and sent to a laboratory to determine if you currently have or once had COVID-19.
When will I get my COVID-19 test results?
In theory, it takes only a few hours for a lab to determine if you've acquired the coronavirus. But depending on where you live, it can take up to a week or more to get your results back. It also depends on how many tests have been administered in your location and where you got the test.Â
Some people may have their tests prioritized, for example if your hospital requires a test before you undergo any type of medical procedure.Â
In any area where mass numbers of people are being tested for COVID-19, backups at processing facilities could lead to a longer wait time for results. The same is true if the lab that processes your test is far from your testing facility -- transporting the samples and processing them will add to the time.
Some Walgreens locations can get your test results back within hours of being administered. However, it depends on the test kit that's used.
Once your results are available, your doctor will contact you to let you know if you've tested positive or negative for COVID-19. You may also receive a letter in the mail detailing your results.
What if I test positive for the coronavirus?
If results show that you've been infected with COVID-19, make sure to let everyone you've come in close contact with in the last two weeks know. Ask your doctor for the next steps. We also have some guidelines for taking care of yourself if you're infected with the virus.
Contact tracing, which is a system that helps identify people you've come into close contact with, can help stem the spread to others.Â
The CDC says you can leave the house again once you've had no fever for at least 24 hours (without medicine), symptoms like coughing have improved and at least 10 days have passed since your symptoms first appeared, but you should seek guidance from your doctor on when it's safe to leave the house.
For more information on coronavirus testing, here's how to find a coronavirus testing site near you and check wait times and who qualifies for COVID-19 testing.